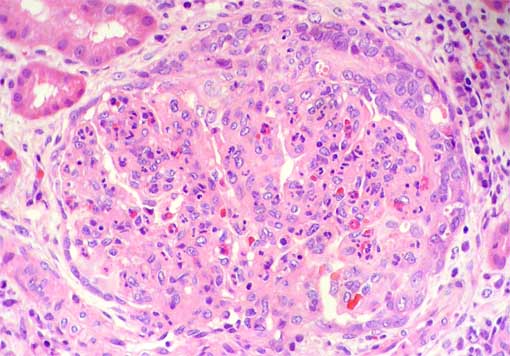

|
CASE 37 (March 2009)
Clinical information
The patient is a 12-year-old girl. She
presented with a 3-weeks history of subjective fever, legs and face edema,
and dyspnea. She has presented dark urine and skin lesions in her left
leg. On physical examination she presents increased blood pressure (140/100
mm Hg) and scar lesions in her left leg that could correspond to healed
pyodermitis.
On questioning, the patient reported
having had treated malaria one year ago; she does not know the Plasmodium
species.
Laboratory tests: Mild normochromic anemia;
the white-cell count was 6,900 per cubic millimeter (40.8% neutrophils,
34.7% lymphocytes); platelets 297,000. Urinalysis: proteinuria: 2,183
mg/24h, leucocytes: 12 hpf; erythrocytes: 40 hpf; granular casts: 3 hpf.
Serum creatinine: 1.1 mg/dL; BUN 27 mg/dL; creatinine clearance: 68 mL/min.
ASLO: 392; ANAs 1/160 speckled pattern;
anti-DNA: 1/20 (two tests); ENAs: Negative. C3: 15 (90-180); C4 39 (10-40).
A renal biopsy is carried out. See
the images.

Figure 1.
H&E, X100.
Figure 2.
H&E, X400.

Figure 3.
H&E, X400.

Figure 4.
Methenamine-silver stain, X400.

Figure 5.
Masson's trichrome stain, X400.

Figure 6.
Masson's trichrome stain, X1,000.

Figure 7.
Direct immunofluorescence using antiserum to IgG,
X400.

Figure 8.
Direct immunofluorescence using antiserum to C3,
X400.

Figure 9.
Immunohistochemical stain for C4d in paraffin-embedded
tissue (policlonal antibody, Biomedica Gruppe, Austria), X400.
Direct immunofluorescence for IgM: parietal,
segmental positivity; IgA and C1q: negative.
What is your diagnosis?
See
diagnosis and discussion
[Top]
|